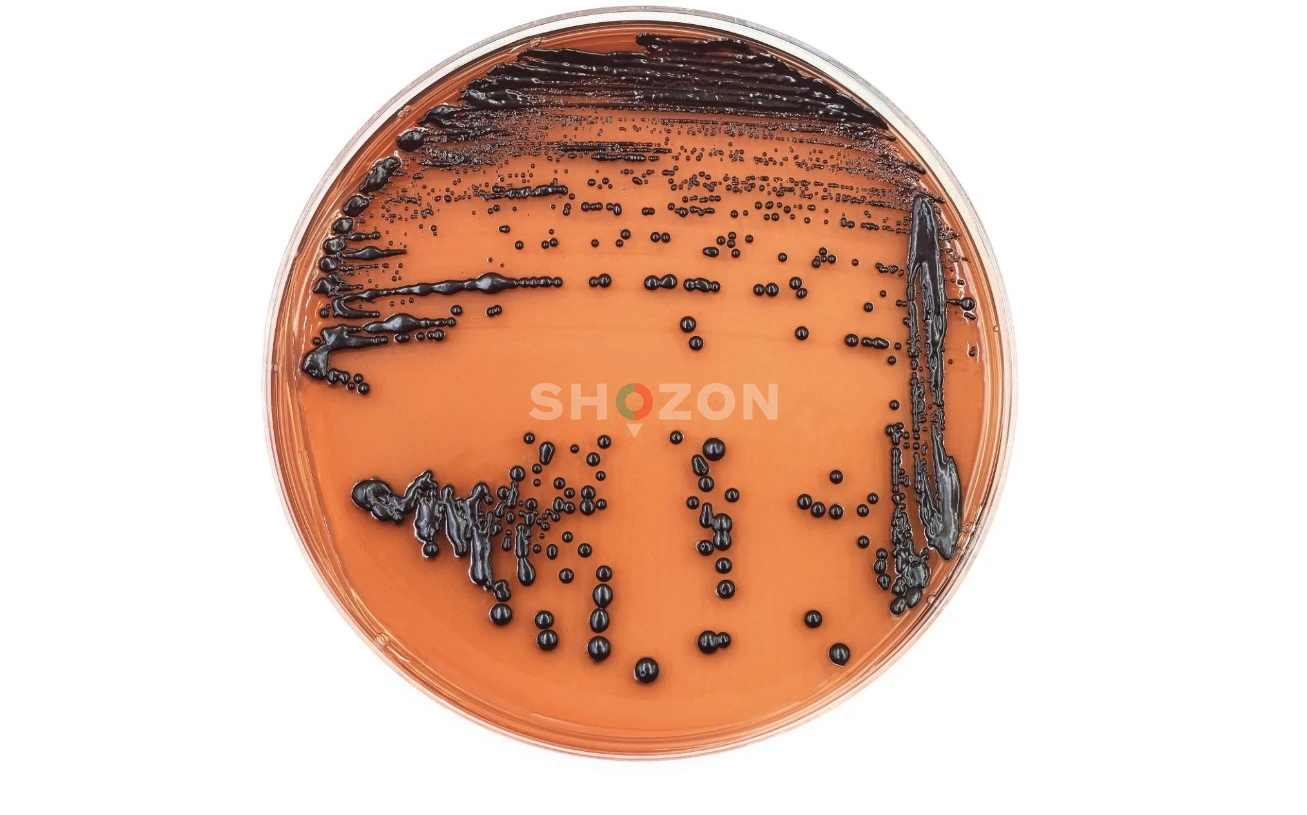
Laboratory Technician

Job description
I have a Master’s degree in Microbiology and experience working in a medical laboratory. My work involved collecting and analyzing clinical samples such as blood, urine, and other body fluids to detect microorganisms including bacteria, viruses, and fungi. I performed laboratory tests, prepared culture media, and assisted in identifying pathogens to help diagnose infectious diseases. I am also familiar with laboratory safety protocols and accurate documentation of test results